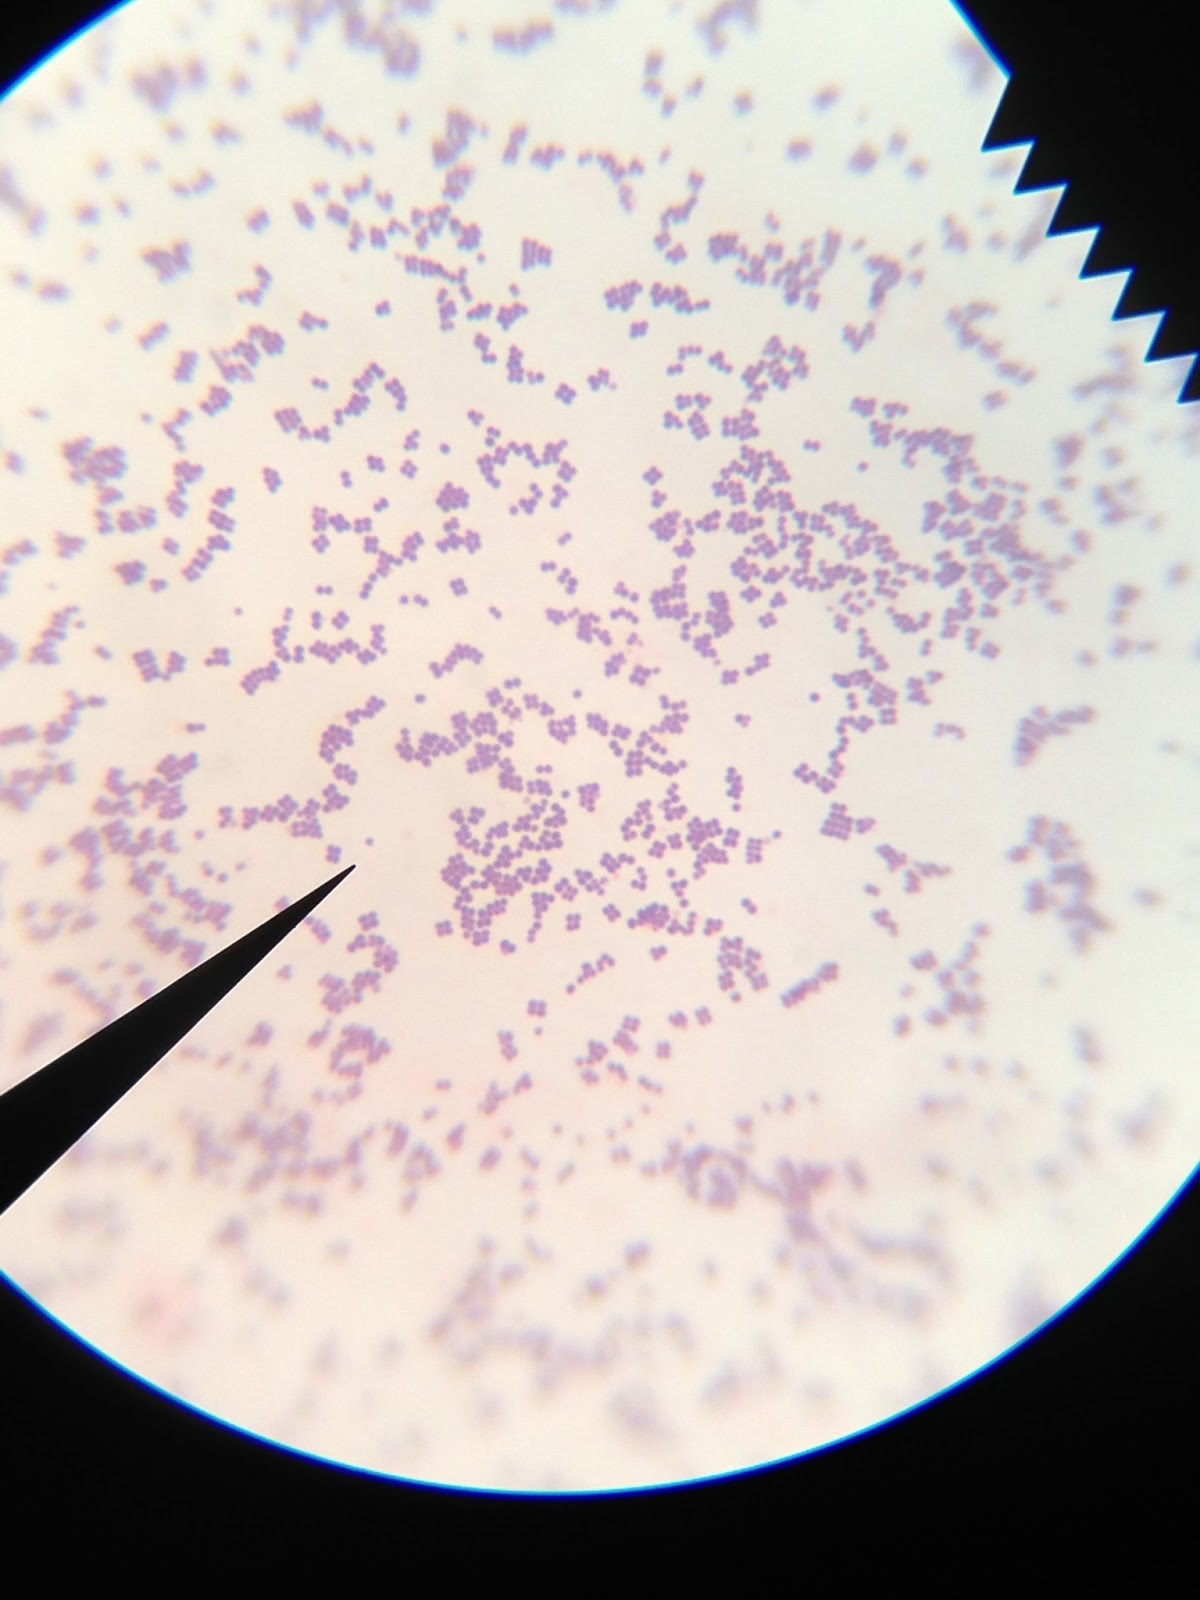

Staining Away:Acid-fast and Endospore Staining of Bacteria J
Class: Thursday September 26, 2013
Our tests today were so full of color! We used two different stain types, as we continue to whittle away at the mystery of Bacteria J. Just to recap, staining techniques are used so that colorless and transparent bacteria can be seen under the microscope. The stains help us to see the morphology and learn about the bacteria's chemical make-up, depending on the stain being used.
First, we did an Acid-fast stain. This staining technique is used to differentiate mycobacterium, such as those that cause leprosy and tuberculosis from other species. Let's pray that Dr. P didn't give us a sample of either of these! Acid-fast stain differentiates mycobacterium in this way; the mycobacterium have waxes in their cell wall that usually repel any stain color. When they are heated with steam, however the waxes soften and stain can enter. The bacterium are then cooled, which solidifies the wax again, keeping the stain in cell. Other bacteria, which don't have waxy cell walls will not hold the stain when rinsed with the decolorizing agent (acid alcohol).

First, Juliet fixed Bacteria J to a clean slide, and then placed it on a staining rack over a beaker of boiling water. The steam from the water softens the waxes in the cell wall. To keep the stain in place (the steam could make it run too much) Sierra placed Bilbous paper on top of the slide and then saturated the entire slide with carbol fuchsin.
![]() |
| Sierra and Juliet kept Matt in line with not letting the stain get dry...he gets distracted so easily! |

It was very important during this part of the procedure to keep the slide and paper constantly flooded with carbol fuchsin, so the whole cell could be thoroughly stained. The slide was heated and colored for 5 minutes....
...and then removed and allowed to cool over the sink. The cooling process is what 'fastens' the stain into the cell wall because during this time the waxes solidify, holding the stain in place. Matt rinsed the slide with DiH2O...
...and then rinsed it again with acid alcohol until the color ran clear. This is a decolorizing agent that removes any stain not held in place by the wax in the cell wall. If the specimen is a mycobacterium, the
![]() |
| Rinsing slide with decolorizing agent |
stain will be held in place and not removed by the decolorizing agent.
![]() |
| Flooding with methylene blue |
The next step allows us to see the bacteria itself. Matt flooded the slide with methylene blue, allowed it to rest for two minutes and then rinsed the whole slide with DiH20. After blotting gently with Bilbous paper, our slide was ready for viewing. So has Dr. P been exposing us to dangerous bacteria again??
![]() |
| DiH2O rinse |
Nah. Dr. P would never do that! There is no red or pink color whatsoever, which would be visible if these bacteria were a mycobacterium species. Only blue as far as the eye can see, which comes from the methylene blue stain used. Phew!
Next task to learn more about Bacteria J: endospore stain. The stain used is Malachite green. Like the acid-fast stain, heat is used to permeate stain the into the endospore itself. The thick protein coat of the endospore does not allow simply staining to take hold, which is why heat and a different stain are necessary, but the protein also holds the stain in the endospore through a rinse of water and safranin. 

The procedure itself is very similar to acid-fast staining, except the slide is heated over steaming water for a few minutes longer (5-6 mins total to be exact). Here's a quick picture recap:
![]() |
| Slide over Malachite green stain. |
![]() |
| A precarious removal. We thought the whole thing was going to end up in the water. Matt is going to be watched carefully from now on. |
![]() |
| After cooling, the slide is rinsed with DiH2O. |
Next, the slide is covered in safranin stain, which then sits for about a minute and a half. The safranin stains the rest of the bacteria, but not the endospore, which will remain green. If endospores are present, the slide should look very Christmasy under the microscope. ![]() |
| Rinsing safranin from slide |
![]() |
| Look at that beautiful slide. |
The last few steps are pretty standard for us by now; rinse the slide with DiH2O for 30 seconds, blot gently, and appreciate our fine work.
![]() |
| Blotting gently |
So is it Christmas come early in the microbio lab?
No, not for this group. Although our stain is looking mighty fine as it is. Good work team.
Final order of random business: Dr. P gave us a bacteriophage last week, which we put on a spread plate with Bacteria J. This was to demonstrate how bacteriophages kill any bacteria they touch. It ever-so-sightly prevented bacterial growth in the pattern that we applied the phage, but not by much (the pattern was supposed to be our initials, JSM).